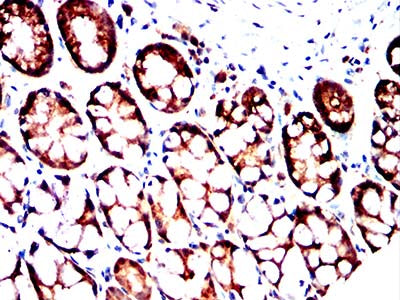

Mouse Monoclonal Antibody to MRP3
货号:
32411
别名:
MLP2; MRP3; ABC31; MOAT-D; cMOAT2; EST90757
应用:
IHC,FCM
反应种属:
Human, Mouse, Rat
抗体类型:
Primary antibody
Swissprot:
O15438
规格:
目录价
在线咨询
Description |
|---|
The protein encoded by this gene is a member of the superfamily of ATP-binding cassette (ABC) transporters. ABC proteins transport various molecules across extra- and intra-cellular membranes. ABC genes are divided into seven distinct subfamilies (ABC1, MDR/TAP, MRP, ALD, OABP, GCN20, White). This protein is a member of the MRP subfamily which is involved in multi-drug resistance. The specific function of this protein has not yet been determined; however, this protein may play a role in the transport of biliary and intestinal excretion of organic anions. Alternatively spliced variants which encode different protein isoforms have been described; however, not all variants have been fully characterized. |
References |
|---|
| 1.Adv Biol Regul. 2019 Aug;73:100634. 2.Mol Genet Genomic Med. 2020 Jun;8(6):e1124. |
Specification |
|
|---|---|
| Aliases | MLP2; MRP3; ABC31; MOAT-D; cMOAT2; EST90757 |
| Entrez GeneID | 8714 |
| Swissprot | O15438 |
| clone | 5F9B12 |
| WB Predicted band size | 43kDa |
| Host/Isotype | Mouse IgG1 |
| Antibody Type | Primary antibody |
| Storage | Store at 4°C short term. Aliquot and store at -20°C long term. Avoid freeze/thaw cycles. |
| Species Reactivity | Human, Mouse, Rat |
| Immunogen | Purified recombinant fragment of human MRP3 (AA: 830-949) expressed in E. Coli. |
| Formulation | Purified antibody in PBS with 0.05% sodium azide |
Application |
|
|---|---|
| IHC | 1/200 - 1/1000 |
| FCM | 1/200 - 1/400 |
| ELISA | 1/10000 |
Product Image
-
Black line: Control Antigen (100 ng);Purple line: Antigen (10ng); Blue line: Antigen (50 ng); Red line:Antigen (100 ng)

-
Flow cytometric analysis of HepG2 cells using MRP3 mouse mAb (green) and negative control (red).

-
Immunohistochemical analysis of paraffin-embedded human lung cancer tissues using MRP3 mouse mAb with DAB staining.

-
Immunohistochemical analysis of paraffin-embedded human cervical cancer tissues using MRP3 mouse mAb with DAB staining.

-
Immunohistochemical analysis of paraffin-embedded human colon cancer tissues using MRP3 mouse mAb with DAB staining.

-
Immunohistochemical analysis of paraffin-embedded breast cancer tissues using MRP3 mouse mAb with DAB staining.

-
Immunohistochemical analysis of paraffin-embedded mouse colon tissues using MRP3 mouse mAb with DAB staining.

-
Immunohistochemical analysis of paraffin-embedded mouse spleen tissues using MRP3 mouse mAb with DAB staining.

-
Immunohistochemical analysis of paraffin-embedded rat kidney tissues using MRP3 mouse mAb with DAB staining.

-
Immunohistochemical analysis of paraffin-embedded rat spleen tissues using MRP3 mouse mAb with DAB staining.

-
Immunohistochemical analysis of paraffin-embedded rabbit rectum tissues using MRP3 mouse mAb with DAB staining.

鄂公网安备42018502007531号

